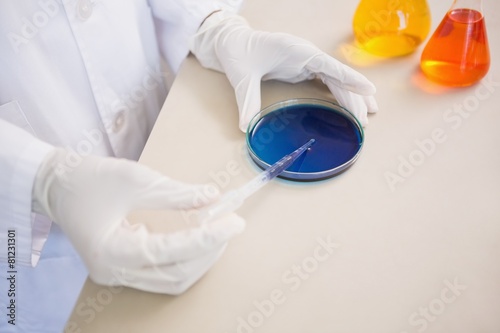

Scientist examining petri dish
Schlüsselwörter
part of,
man,
woman,
science,
laboratory,
laboratory,
biology,
scientist,
medicine,
technology,
equipment,
labcoat,
examining,
studying,
medicals,
biotechnology,
biochemistry,
chemist,
chemistry,
chemical,
holding,
beaker,
pipette,
indoor